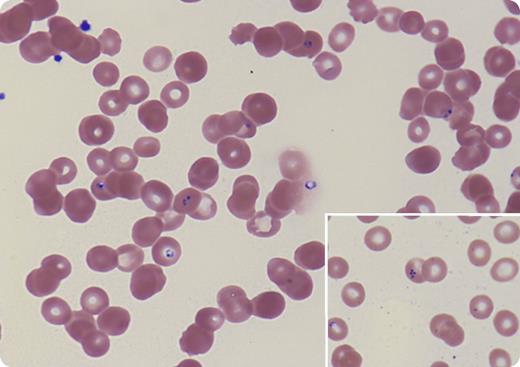
A 34-year-old man with myelofibrosis underwent HLA-matched unrelated donor hematopoietic stem cell transplantation (HSCT) with major ABO incompatibility, complicated by pure red cell aplasia requiring red blood cell transfusion for several months, and by graft-versus-host disease treated with corticosteroids, tacrolimus, and rituximab with subsequent hypogammaglobulinemia. At 14 months post-HSCT, his anemia was starting to improve with decreasing isohemagglutinin level when he presented with fever, headache, malaise, and profound anemia. Lactate dehydrogenase and bilirubin were elevated, haptoglobin was low, and direct antiglobulin test was negative, consistent with nonimmune hemolytic anemia. Peripheral blood showed intraerythrocyte ring forms with central pallor and a merozoite arranged in tetrad configuration resembling a Maltese cross (inset; Wright stain, original magnification ×100 for main panel and inset). Polymerase chain reaction confirmed Babesia microti. The patient denied history of tick bite but lived in an area where Ixodes scapularis is endemic. He was treated with doxycycline, clindamycin, and atovaquone for 6 weeks. His anemia and hemolysis quickly improved and the parasitemia resolved within 2 weeks. / Babesiosis, a tick-borne malaria-like illness, is transmitted via bites by infected Ixodes scapularis and through blood donation from affected asymptomatic individuals. Immunosuppressed patients are more susceptible to infection. Our case illustrates the importance of blood smear review even when other causes of anemia are obvious and underscores that babesiosis can be a cause of post-HSCT anemia.

A 34-year-old man with myelofibrosis underwent HLA-matched unrelated donor hematopoietic stem cell transplantation (HSCT) with major ABO incompatibility, complicated by pure red cell aplasia requiring red blood cell transfusion for several months, and by graft-versus-host disease treated with corticosteroids, tacrolimus, and rituximab with subsequent hypogammaglobulinemia. At 14 months post-HSCT, his anemia was starting to improve with decreasing isohemagglutinin level when he presented with fever, headache, malaise, and profound anemia. Lactate dehydrogenase and bilirubin were elevated, haptoglobin was low, and direct antiglobulin test was negative, consistent with nonimmune hemolytic anemia. Peripheral blood showed intraerythrocyte ring forms with central pallor and a merozoite arranged in tetrad configuration resembling a Maltese cross (inset; Wright stain, original magnification ×100 for main panel and inset). Polymerase chain reaction confirmed Babesia microti. The patient denied history of tick bite but lived in an area where Ixodes scapularis is endemic. He was treated with doxycycline, clindamycin, and atovaquone for 6 weeks. His anemia and hemolysis quickly improved and the parasitemia resolved within 2 weeks.
Babesiosis, a tick-borne malaria-like illness, is transmitted via bites by infected Ixodes scapularis and through blood donation from affected asymptomatic individuals. Immunosuppressed patients are more susceptible to infection. Our case illustrates the importance of blood smear review even when other causes of anemia are obvious and underscores that babesiosis can be a cause of post-HSCT anemia.
A 34-year-old man with myelofibrosis underwent HLA-matched unrelated donor hematopoietic stem cell transplantation (HSCT) with major ABO incompatibility, complicated by pure red cell aplasia requiring red blood cell transfusion for several months, and by graft-versus-host disease treated with corticosteroids, tacrolimus, and rituximab with subsequent hypogammaglobulinemia. At 14 months post-HSCT, his anemia was starting to improve with decreasing isohemagglutinin level when he presented with fever, headache, malaise, and profound anemia. Lactate dehydrogenase and bilirubin were elevated, haptoglobin was low, and direct antiglobulin test was negative, consistent with nonimmune hemolytic anemia. Peripheral blood showed intraerythrocyte ring forms with central pallor and a merozoite arranged in tetrad configuration resembling a Maltese cross (inset; Wright stain, original magnification ×100 for main panel and inset). Polymerase chain reaction confirmed Babesia microti. The patient denied history of tick bite but lived in an area where Ixodes scapularis is endemic. He was treated with doxycycline, clindamycin, and atovaquone for 6 weeks. His anemia and hemolysis quickly improved and the parasitemia resolved within 2 weeks.
Babesiosis, a tick-borne malaria-like illness, is transmitted via bites by infected Ixodes scapularis and through blood donation from affected asymptomatic individuals. Immunosuppressed patients are more susceptible to infection. Our case illustrates the importance of blood smear review even when other causes of anemia are obvious and underscores that babesiosis can be a cause of post-HSCT anemia.
For additional images, visit the ASH IMAGE BANK, a reference and teaching tool that is continually updated with new atlas and case study images. For more information visit http://imagebank.hematology.org.